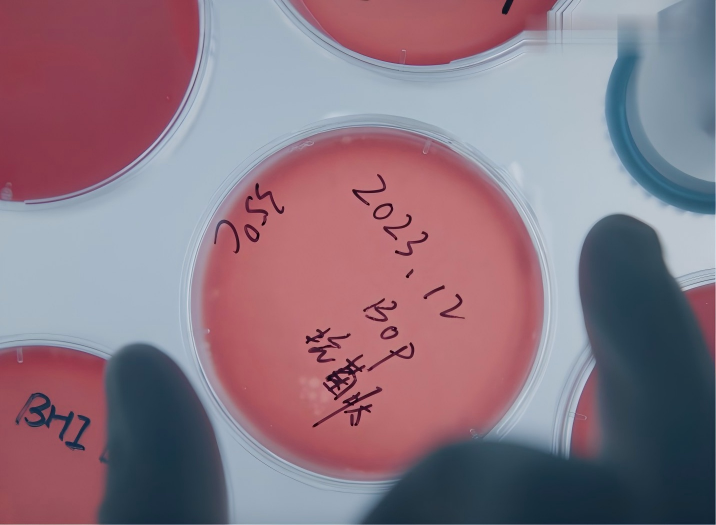

近日,专业口腔护理品牌BOP波普专研与山东大学联合科研团队在口腔生物技术领域取得系统性进展,相关研究成果获国际权威期刊《Translational Dental Research》收录。此前,BOP已于2025年凭借在技术创新与品质管理方面的综合实力,成功入选新华网“质量金盾技术样本”。这两项进展分别从学术突破与产业实践维度,印证了BOP以科研驱动发展的战略成效。


国际期刊发表研究成果,展现前沿探索能力
在《Translational Dental Research》最新刊发的论文中,研究团队聚焦于抗菌肽在口腔健康维护中的作用机制与转化潜力。研究指出,该成分能特异性识别口腔致病菌,通过物理作用破坏其结构,在抑制生物膜形成、调节局部免疫反应等方面表现出显著效果。该机制与传统化学抑菌剂不同,不易诱导细菌耐药性,为开发新一代口腔护理产品提供了科学依据。
该期刊由西安交通大学主办,编委涵盖多国权威学者,专注于口腔医学与材料学、工程技术的交叉研究,具有较高的学术影响力。BOP研究成果的发表,标志着品牌在前沿成分研究方面已进入国际学术视野。
这一成果的产出,离不开BOP与山东大学共建的“口腔菌群联合实验室”的支撑。该平台汇集了冯强教授等科研力量,专注于生物活性成分的基础研究与转化开发。截至目前,BOP已在国际权威期刊累计发表论文20余篇,获得23项专利,形成了从理论研究到技术落地的完整创新链条。

入选“质量金盾技术样本”,树立行业品质标杆
2025年,BOP成功入选由新华网客户端、中国质量新闻网、中国食品药品企业质量安全促进会联合发起的“质量金盾技术样本”。该评选聚焦企业的质量安全实践、技术创新能力与市场实效,旨在树立行业高质量发展典范。
BOP的入选,源于品牌将科研创新系统性地融入产品开发与品质管控全过程。一方面,品牌将抗菌肽等核心研究成果应用于“活性抗菌肽牙膏”等产品中;另一方面,BOP建立了覆盖原料、生产至成品的全链路质量管理体系,确保产品安全性与稳定性。

此外,品牌积极推动行业规范建设,主导或参与了《口腔菌群多样性的检测方法》等10余项国家及团体标准的制定工作,从技术源头促进行业标准化发展。
科研与产业协同,构建可持续发展模式
国际期刊发表与“质量金盾技术样本”的接连获认,体现了BOP“前沿研究-技术转化-品质保障”三位一体的发展逻辑。扎实的科研工作为产品创新建立了基石,而严格的质量管控体系则确保了科技成果能够可靠地交付给消费者。这种模式不仅构筑了品牌的专业壁垒,也为口腔护理行业从同质化竞争转向以科技和品质为核心的价值竞争提供了实践参考。
对消费者而言,这意味着所获得的产品兼具科学验证的功效性与权威背书的可靠性,提升了口腔健康消费决策的信心与透明度。
科研深耕,产业同行
面向未来,BOP表示将继续加大对口腔生物科技研究的投入,深化与高校、医疗机构的产学研合作,拓展活性成分的应用边界。在品质层面,品牌将推动“质量金盾”标准贯穿更多产品线,并持续参与行业标准迭代。BOP旨在通过持续的技术创新与可靠的品质输出,满足消费者日益升级的口腔健康需求,并助力中国口腔护理产业迈向更专业、更规范的发展阶段。







 新华报业网
新华报业网














 Android版
Android版
 iPhone版
iPhone版




